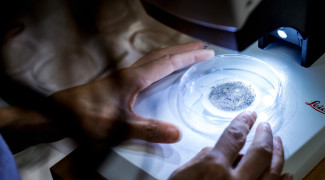
Ympäristötiede_mikromuovi.

The organisation of the University of Eastern Finland comprises the University Collegium, the Board, the Rector and the Vice Rectors, University Services, the faculties, as well as the independent institutes and the service centres.
The university’s leadership is responsible for the overall strategic leadership and decision-making of the university. Our university has four faculties, each with its distinct focus areas in education and research. The faculties are led by the Deans. The independent institutes and the service centres, in turn, concentrate on specific research, education or service-related tasks.
University Services supports the university’s activities by providing, for example, administrative services such as human resources, IT support and educational services.

Leadership and decision-making
Faculties
Philosophical Faculty
- School of Humanities, Joensuu
- School of Educational Sciences and Psychology, Joensuu
- School of Applied Educational Science and Teacher Education, Joensuu
- School of Theology, Joensuu
- UEF Teacher Training School
Faculty of Science, Forestry and Technology
- Department of Physics and Mathematics, Joensuu
- Department of Chemistry and Sustainable Technology, Joensuu
- School of Forest Sciences, Joensuu
- Department of Technical Physics, Kuopio
- School of Computing, Joensuu and Kuopio
- Department of Environmental and Biological Sciences, Joensuu and Kuopio
Faculty of Health Sciences
- A.I. Virtanen Institute for Molecular Sciences, Kuopio
- School of Pharmacy, Kuopio
- Department of Nursing Science, Kuopio
- School of Medicine, Kuopio
- Institute of Biomedicine, Kuopio
- Institute of Clinical Medicine, Kuopio
- Institute of Dentistry, Kuopio
- Institute of Public Health and Clinical Nutrition, Kuopio
- Biocenter Kuopio
Faculty of Social Sciences and Business Studies
- Department of Geographical and Historical Studies, Joensuu
- UEF Business School, Joensuu and Kuopio
- UEF Law School, Joensuu
- Department of Health and Social Management, Kuopio
- Department of Social Sciences, Joensuu and Kuopio
- Karelian Institute, Joensuu
Independent institutes and service centres
University Services
Leadership and decision-making
The highest decision-making body at our university is the Board. It determines the university’s key objectives and strategy.
Responsibility for the university’s administration lies with the Board, the Rector and two Vice Rectors, the University Collegium, the Faculty Councils and the Deans. For day-to-day administrative tasks, the university is supported by University Services.
Rectors of the university
The university has a Rector and two Vice Rectors. Rector Tapio Määttä leads the university’s activities and carries out the duties assigned to the Rector by the Universities Act. Vice Rector Jussi Pihlajamäki is responsible for research at our university, while Vice Rector Laura Hirsto oversees education. The Rectors operate on both campuses.
The Board decides on the central goals and strategy of the university. The Board also elects the Rectors of the university.
The Board of the University of Eastern Finland is composed of a total of 10 members, four of whom are external members. The new Board will take office on 1 January 2026. The term of office of the external members and students is two years, and the term of office of the staff representatives is four years.
In 2026, the meeting dates are 13 January, 19 March, 11 June, 8 September, 18 November and 15 December.
The minutes and agendas of UEF Board meetings from 4 May 2020 onwards can be found in the Dynasty service behind this link and of meetings preceding 4 May 2020 behind this link.
The Chair of the Board is Siamäk Naghian and the Vice Chair is Marko Korhonen.
PhD Kirsi Helkala is Professor of Cyber Security at the Norwegian Defence University College. She has also worked as Head of Research and member of the management group of the Norwegian Defence Cyber Academy (NDCA) since 2018. Helkala’s previous roles include Research Professor at Peace Research Institute Oslo in 2020–2023, Associate Professor in 2010–2013 and Researcher in 2004–2010 at Gjøvik University College (now Norwegian University of Science and Technology), and Lecturer at the University of Joensuu in 2001–2002. Helkala received her doctoral degree in the field of information security from the University of Oslo and, before that, graduated as a teacher of mathematics, physics and chemistry from the University of Joensuu.
DSocSc Marko Korhonen is Director of the Wellbeing Services County of North Savo. He was appointed to his current position in 2022, before which he worked as Region Mayor of North Savo in 2016–2022. Korhonen’s previous roles include Municipal Manager and Director of Administration of the joint municipal authority in 2008–2016 and CEO of the Social Services Foundation in 2000–2008. At the moment, he is, e.g., Chair of the network of the Directors of Finnish Wellbeing Services Counties and a member of the national Advisory Board for Wellbeing Services Counties. Korhonen was a member of the Kuopio University Foundation’s board in 2016–2025. In 2022, Korhonen was selected as the alumnus of the year of the University of Eastern Finland.
DSc (Tech.) Siamäk Naghian is CEO of the Iisalmi-based, internationally renowned sound system developer and manufacturer Genelec. Naghian joined Genelec in 2005. Before becoming the company’s CEO in 2011, he worked as the company’s R&D Director and Executive Vice President. Naghian has also worked for Nokia in various research and development positions and leadership roles. Naghian received his doctoral degree in Technology from the Helsinki University of Technology (currently Aalto University). He has published several articles related to mobile networks and mobile applications and is one of the editors of a book on UMTS networks. He holds numerous patents in the field of wireless and mobile networks and sound reproduction systems. In 2018, Naghian was selected as the Enterprise Executive of the Year in Finland and in 2020, the alumnus of the year of the Aalto University School of Electrical Engineering. Innovation management and the utilisation of innovations to promote the wellbeing of society and the environment are close to Siamäk’s heart, together with science, art and culture.
M.A. Erja Yläjärvi is Senior Editor-in-Chief at Helsingin Sanomat. Earlier in her career, she has also worked as Managing Editor at Helsingin Sanomat. Before moving to Helsingin Sanomat, Yläjärvi was Senior Editor-in-Chief at Hufvudstadsbladet and, before that, Senior Editor-in-Chief at Iltalehti. During her journalistic career, Yläjärvi has focused, above all, on societal topics, and has previously worked as Correspondent for the Finnish News Agency STT in Brussels. She holds a Master’s degree in Social Sciences from the University of Tampere with a major in international politics, and a Master of Arts degree in EU studies from the College of Europe in Bruges.
PhD, DSocSc Jopi Nyman is Professor of English Language and Culture and leads the Borders, Mobilities and Cultural Encounters research community at the University of Eastern Finland. His research focuses diversely on the phenomena of English literature, examining them particularly from the perspective of cultural encounters, border studies and human-animal studies. His previous roles include Vice Dean of the Philosophical Faculty at the University of Eastern Finland in 2018–2021 and Vice Chair of the University Collegium in 2010–2017. He is currently Chair of the international MESEA The Society for Multi-Ethnic Studies: Europe and the Americas and Chair of the Administrative Council of the North Karelia Regional Fund of the Finnish Cultural Foundation. He has received a Postgraduate Diploma from the University of East London, UK, and has acted as a visiting professor at the University of Leeds.
PhD Ursula Schwab is Professor of Nutrition Therapy and head of the academic subject of Nutrition. She is actively engaged in research on the effects of diet quality on, e.g., the body’s lipid and glucose metabolism, low-grade inflammation, accumulation of fat in the liver, and health when ageing. Her role also includes clinical work at the Kuopio University Hospital in the Well-being Services County of North Savo. She was Chair of the Research Council for Biosciences, Health and the Environment at the Research Council of Finland in 2019–2021. Currently, she is a member of the Supervisory Board of the Finnish Cultural Foundation, Chair of a Publication Forum panel, a member of the Standing Committee of Nordic Nutrition Recommendations, and a member of the National Nutrition Council of Finland. Ursula Schwab has worked abroad in the JM Human Nutrition Center in Boston, USA, for a year and a half.
DSocSc Saara Koikkalainen is Senior Researcher at the Karelian Institute of the Faculty of Social Sciences and Business Studies on the Joensuu campus. She is a mobility researcher and sociologist, who has studied, e.g., migration decision-making, Finnish expats, Iraqi asylum seekers, immigration policy, and Nordic migrants in London during the Brexit era. She has also worked at the Universities of Lapland and Helsinki and as a project evaluator of the European Commission. Koikkalainen has completed international researcher exchange periods in the United States, Italy, Great Britain and Egypt. She is a member of the Board of Nordic Migration Research and Chair of the working group for Joensuun kirjallisuustapahtuma (Joensuu Literature Event). She has also served as a board member of the Union of Research Professionals and as Chair of the Association of Researchers and Teachers in Eastern Finland.
MSc Tomi Rosti works as Information Specialist and Coordinator of Open Science and Research at the University of Eastern Finland Library on the Joensuu campus. He is the chair of the Staff Association of the University of Eastern Finland and a deputy chief shop steward. He has experience in academic administration and decision-making, thanks to his previous positions of trust. He is Vice Chair and a member of the Board and Working Committee of the Federation of University and Research Staff (YHL), Vice Chair of the University Sector Advisory Board, and a member and deputy board member of the Regional Board of Trade Union Pro. He is also Chair of the Youth Work Support Foundation in North Karelia and STTK’s regional committee for North Karelia, and a member of the Regional Management Committee for North Karelia.
Leevi Haavisto is pursuing a Master’s degree in Social Sciences with the major in social work on the Kuopio campus. During his studies, he has been a member of the Faculty Council of the Faculty of Social Sciences and Business Studies and an active deputy member of the University Collegium in 2024–2025. In addition, he was a member of the Board of the UEF Kuopio Student Choir in 2023–2025, of which Chair of the Board in 2024–2025. He was also a member of the Board of Talentian Sosiaalialan Opiskelijat TaSO ry in 2025.
Bachelor of Arts Lassi Oikkonen is pursuing a Master’s degree in general history and in records management and archiving on the Joensuu campus. Alongside his studies, he has worked as Information Management Planner in internal administration and has also hold other records management posts in the public sector. Oikkonen has been a member of the Council of Representatives of the UEF Student Union since 2020 and was a member of its Board in 2023, a member of the Faculty Council of the Faculty of Social Sciences and Business Studies since 2020, a member of the University Collegium in 2022–2025, and a member of the Board of Appeal in 2022–2023. He was a member of Keskustaopiskelijat ry’s Board in 2022 and the 2nd Vice Chair in 2023. Since the municipal elections, he has acted as a district court lay judge.
Chief Legal Officer Petri Rintamäki, petri.rintamaki(at)uef.fi, acts as the secretary of the UEF Board.

The Board of the University of Eastern Finland in a group photo in January 2026. From left to right: Saara Koikkalainen, Erja Yläjärvi, Tomi Rosti, Lassi Oikkonen, Marko Korhonen, Kirsi Helkala, Siamäk Naghian, Leevi Haavisto, Jopi Nyman and Ursula Schwab.
The University Collegium comprises a total of 24 members. Eight of the members represent the university's professors, eight represent the university's other teaching and research staff and other staff, and eight represent the university's students. The term of office of the University Collegium is four calendar years. The term of office of the members representing the university's students is two calendar years.
Next meeting takes place in Kuopio on 19 March, 2026.
Members (deputy members) of the University Collegium, elected for a four-year term beginning on 1 January 2026.
Professors
- Jaana Rysä (Tarja Välimäki, deputy member)
- Esa Penttilä (Kirsi Honkalampi, deputy member)
- Timo Tokola, Chair (Riitta Vornanen, deputy member)
- Katja Kanninen (Elina Oksanen, deputy member)
- Anssi Keinänen (Serafim Seppälä, deputy member)
- Sonja Kosunen (Pekka Toivanen, deputy member)
- Annakaisa Haapasalo (Olga Davydova-Minguet, deputy member)
- Pasi Karjalainen (Harri Laihonen, deputy member)
Teaching, research and general staff
- Antero Puhakka, 1st Vice-Chair (Kati Kasanen, deputy member)
- Juha Riepponen (Jussi Mäkelä, deputy member)
- Johanna Uotinen (Leila Saramäki, deputy member)
- Kari Kotikumpu (Maija Lahtela-Kakkonen, deputy member)
- Tero Karjalainen (Sanna Pasonen-Seppänen, deputy member)
- Erja Karvinen (Atte Jäntti, deputy member)
- Samu Kainulainen (Ville Kivivirta, deputy member)
- Christina Piel (Juha Karhunen, deputy member)
Students (1.1.2026–31.12.2027)
- Johannes Airaksinen (Ruska Itkonen, deputy member)
- Marko Koskelo (Onni Riikkilä, deputy member)
- Reetta Venäläinen (Päivikki Ojalehto, deputy member)
- Mikko Miettinen (Maria Rossi, deputy member)
- Joonatan Packalén, 2nd Vice-Chair (Bharath Kannan, deputy member)
- Nisha Rathnayaka (Aadish Chauhan, deputy member)
- Ville Salonkangas (Katriina Saarinen, deputy member)
- Eero Terävä (Yoshitha Vidanagamage, deputy member)

Photo: The University Collegium in a group photo 2026.
University Regulations of the University of Eastern Finland are downloadable as PDF file.
Faculties
The university comprises four faculties: the Philosophical Faculty, the Faculty of Science, Forestry and Technology, the Faculty of Health Sciences, and the Faculty of Social Sciences and Business Studies.
Philosophical Faculty
- Dean Ilkka Huhta
- 1st Vice Dean Marja Laasonen (education)
- 2nd Vice Dean Heidi Hyytinen (research)
- Executive Head of Administration Henni Nevalainen
Faculty of Science, Forestry and Technology
- Dean Kari Lehtinen
- 1st Vice Dean Markku Hauta-Kasari (education)
- 2nd Vice Dean Heli Peltola (research)
- Executive Head of Administration Arja Hirvonen
Faculty of Health Sciences
- Dean Markus Forsberg
- 1st Vice Dean Ville Leinonen (research)
- 2nd Vice Dean Arja Lyytinen (education)
- Executive Head of Administration Hanna Ollikainen-Richards
Faculty of Social Sciences and Business Studies
- Dean Matti Turtiainen
- 1st Vice Dean Sari Rissanen (research)
- 2nd Vice Dean Minna Tanskanen (education)
- Executive Head of Administration Marko Junkkarinen
Independent institutes and service centres
The independent institutes and the service centres focus on their specific research, education or service-related tasks. At our university, the University of Eastern Finland Pharmacy is an independent institute, while the service centres include the Centre for Continuous Learning, the Language Centre and the Library. They work in close collaboration with the faculties and University Services.
University Services
University Services supports the Board, the Rectors and the Deans in the preparation and implementation of decisions, and is responsible for the overall administrative services required by the university and its various units.